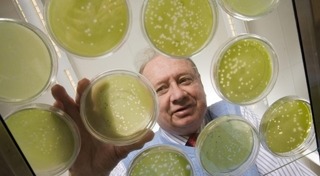

รวมโครงงานวิทยาศาสตร์ในหัวข้อต่าง ๆ การสำรวจ ค้นคว้า ทดลอง ข้อมูลและเกร็ดความรู้ที่น่าสนใจ พร้อมอัปเดตประเด็นข่าวที่เกี่ยวข้อง
รวมโครงงานวิทยาศาสตร์ในหัวข้อต่าง ๆ การสำรวจ ค้นคว้า ทดลอง ข้อมูลและเกร็ดความรู้ที่น่าสนใจ พร้อมอัปเดตประเด็นข่าวที่เกี่ยวข้อง

 จะเกิดอะไรขึ้น! เมื่อ แช่น้ำอัดลมกระป๋อง ด้วยไนโตรเจนเหลว
จะเกิดอะไรขึ้น! เมื่อ แช่น้ำอัดลมกระป๋อง ด้วยไนโตรเจนเหลว
 เกิดอะไรขึ้น เมื่อคุณโยน แท่งโซเดียม ลงในแม่น้ำ ?
เกิดอะไรขึ้น เมื่อคุณโยน แท่งโซเดียม ลงในแม่น้ำ ?
 จุดไม้ขีดด้วยหนังยาง ทำได้ง่ายๆ แต่เจ๋งโคตร
จุดไม้ขีดด้วยหนังยาง ทำได้ง่ายๆ แต่เจ๋งโคตร
 ทดลองสุดแปลก ! เมื่อนำ เมือกปลาไหล มาใส่ในน้ำ ผลออกเป็นยังไง ต้องดู
ทดลองสุดแปลก ! เมื่อนำ เมือกปลาไหล มาใส่ในน้ำ ผลออกเป็นยังไง ต้องดู
 สร้างชื่อ ! มนุษย์อวกาศญี่ปุ่น เลือก 2 ไอเดียของเด็กไทยไปสาธิตในอวกาศ
สร้างชื่อ ! มนุษย์อวกาศญี่ปุ่น เลือก 2 ไอเดียของเด็กไทยไปสาธิตในอวกาศ
 มทร.ธัญบุรี เครื่องแปลงตัวอักษรเป็นเสียงพูดควบคุม ด้วยระบบไร้สายต้นแบบ
มทร.ธัญบุรี เครื่องแปลงตัวอักษรเป็นเสียงพูดควบคุม ด้วยระบบไร้สายต้นแบบ
 เครื่องให้อาหารอัตโนมัติ พลังงานแสงอาทิตย์
เครื่องให้อาหารอัตโนมัติ พลังงานแสงอาทิตย์
 มจธ. เปิดตัว กังหันลมแนวนอน ขนาด 1 กิโลวัตต์
มจธ. เปิดตัว กังหันลมแนวนอน ขนาด 1 กิโลวัตต์
 จะเกิดอะไรขึ้น เมื่อเอามีด แทงแบตเตอรี่โทรศัพท์มือถือ!
จะเกิดอะไรขึ้น เมื่อเอามีด แทงแบตเตอรี่โทรศัพท์มือถือ!
 ภาพโหด หมา 2 ตัว ถูกนักวิทยาศาสตร์จับมาทดลอง สิ่งที่คุณคาดไม่ถึง !
ภาพโหด หมา 2 ตัว ถูกนักวิทยาศาสตร์จับมาทดลอง สิ่งที่คุณคาดไม่ถึง !
อึ้งเลย นักวิทย์ค้นพบไวรัสที่ทำให้คนฉลาดน้อยลง
อึ้งเลย นักวิทย์ค้นพบไวรัสที่ทำให้คนฉลาดน้อยลง
 สารเติมเลือด นวัตกรรมใหม่ของทีมวิจัย ม.นเรศวร
สารเติมเลือด นวัตกรรมใหม่ของทีมวิจัย ม.นเรศวร